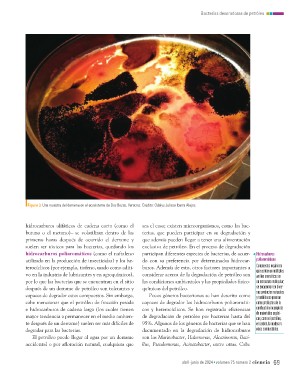

Page 71 - Ciencia 75-2
P. 71
Bacterias devoradoras de petróleo ■ ■■
■ Figura 3. Una muestra del derrame en el ecosistema de Dos Bocas, Veracruz. Crédito: Odalys Julissa Ibarra Alejos.
hidrocarburos alifáticos de cadena corta (como el sea el caso; existen microorganismos, como las bac- Hidrocarburos
butano o el metano)– se volatilizan dentro de las terias, que pueden participar en su degradación y poliaromáticos
primeras horas después de ocurrido el derrame y que además pueden llegar a tener una alimentación
suelen ser tóxicos para las bacterias, quedando los exclusiva de petróleo. En el proceso de degradación Compuestos orgánicos
hidrocarburos poliaromáticos (como el naftaleno participan diferentes especies de bacterias, de acuer- que contienen múltiples
utilizado en la producción de insecticidas) y los he- do con su preferencia por determinados hidrocar- anillos aromáticos en
terocíclicos (por ejemplo, tiofeno, usado como aditi- buros. Además de esto, otros factores importantes a su estructura molecular;
vo en la industria de lubricantes y en agroquímicos), considerar acerca de la degradación de petróleo son se encuentran en diver-
por lo que las bacterias que se encuentran en el sitio las condiciones ambientales y las propiedades fisico- sos productos naturales
después de un derrame de petróleo son tolerantes y químicas del petróleo. y también se generan
capaces de degradar estos compuestos. Sin embargo, como productos de la
cabe mencionar que el petróleo de fracción pesada Pocos géneros bacterianos se han descrito como combustión incompleta
e hidrocarburos de cadena larga (los cuales tienen capaces de degradar los hidrocarburos poliaromáti- de materiales orgáni-
mayor tendencia a permanecer en el medio ambien- cos y heterocíclicos. Se han registrado eficiencias cos, como el petróleo,
te después de un derrame) suelen ser más difíciles de de degradación de petróleo por bacterias hasta del el carbón, la madera y
degradar para las bacterias. 95%. Algunos de los géneros de bacterias que se han otros combustibles.
documentado en la degradación de hidrocarburos
El petróleo puede llegar al agua por un derrame son las Marinobacter, Halomonas, Alcanivorax, Baci-
accidental o por afloración natural, cualquiera que llus, Pseudomonas, Acinetobacter, entre otras. Cabe
abril-junio de 2024 ♦ volumen 75 número 2 ciencia 69